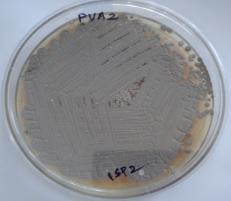

Int J Pharm Pharm Sci, Vol 6, Issue 7, 475-480Original Article
OPTIMIZATION OF MEDIUM COMPONENTS FOR ANTIBACTERIAL METABOLITE PRODUCTION FROM MARINE STREPTOMYCES SP. PUA2 USING RESPONSE SURFACE METHODOLOGY
P. SHEKAR1, K.SATHISH KUMAR1, S.ANURADHA JABASINGH2, M. RADHAKRISHNAN3, R. BALAGURUNATHAN4,*
1Department of Chemical Engineering, SSN College of Engineering, Chennai 600110, Tamil Nadu, India, 2Departmnet of Chemical Engineering, Sathyabama University, Chennai 600119, Tamil Nadu, India, 3Centre for Drug Discovery and Development, Sathyabama University, Chennai 600119, Tamil Nadu, India, 4Department of Microbiology, Periyar University, Salem 636011, Tamil Nadu, India
Email: rbalaguru@yahoo.com
Received: 10 May 2014 Revised and Accepted: 20 June 2014
ABSTRACT
Objective: The present study is an attempt to optimize the fermentation conditions for the antibacterial compound production from a newly isolated marine Streptomyces strain PUA2 by adopting response surface methodology as the statistical tool.
Methods: Prior to using the Response Surface Methodology, Plackett Burmann (PB) design was used to explore the effect of variables on the antibacterial compound production. In PB method, high and low values were assigned for the eight variables viz., glucose, glycerol, soybean meal, manganese chloride, calcium carbonate, peptone and pH. Calcium carbonate and peptone were used as dummy variables. Based on the results of combined effects glycerol, soybean meal, manganese chloride and pH were investigated by 24 full-factorial central composite design.
Results: The results of PB method showed the significant effect of glycerol, soybean meal, manganese chloride and pH on the antibacterial compound production. The results of ANOVA and regression of second order model showed that the linear effects of glycerol and manganese chloride and cross products effects of manganese chloride and pH were more significant. All the critical variables having greatest effect on the production of antibacterial compound from marine Streptomyces species PUA2. Optimization of process parameters resulted in increase in antibacterial activity from 7 mm to 14 mm.
Conclusion: The factors optimized in the present study were useful for the increased production of antibacterial metabolite from Streptomyces sp PUA2. The result confirms the feasibility of medium optimization to improve antibiotic production.
Keywords: Antibacterial activity, Marine actinobacteria, Central Composite Design, Plackett Burmann design, Response surface methodology.
INTRODUCTION
Marine actinobacteria are metabolically active and physiologically adoptive to growth in sea water. They are the promising source for novel secondary metabolites with different biological activities like antimicrobial, anticancer, antiviral, anti-inflammatory and antiparasitic, etc. Even with the limited screening efforts dedicated to date to marine actinobacteria, the discovery rate of novel secondary metabolites from marine actinobacteria has recently surpassed that of their terrestrial counterparts, as evident by the isolation of many new chemical entities from marine actinobacteria [1-2]. During the period of 2003-2005, years, 659 marine bacterial compounds have been described in which 256 compounds have originated from actinobacteria [3].
Bioactive metabolites from actinobacteria are commonly produced by submerged or solid state fermentation with one or two commonly used media. Optimizing the suitable conditions and medium components is a prerequisite for better production of antibiotics or any other metabolites. Medium optimization explores a sequence of phases with a specific set of optimal conditions fixed by different methodologies.
Nutritional aspects like carbon source, nitrogen source and minerals and other conditions like time of incubation, pH and temperature are known to have profound effect on the production of antimicrobial metabolites by actinobacteria. Hence optimization of culture conditions is very essential to get maximum yield of antimicrobial metabolites [4-6].The optimization of the medium by the conventional research technique, the classical one factor at a time method involves changing one independent variable like carbon source and nitrogen source, while fixing others at constant levels. Optimal medium is not always obtainable by the traditional one factor at a time optimization strategy because of potential interactions among medium components [7]. PB design is a well known and widely used statistical technique for screening and selection of most significant culture variables. PB design offers a good and fast screening procedure and mathematically it computes the significance of a large number of factor variables in one experiment, which saves time and maintains convincing information on each component [8-9]. This method allows the screening of main factors from a large number of experiments that can be retained in further optimization processes.
RSM is a powerful technique for testing multiple process variables owing to fewer experimental trials that are needed compared to the study of one variable at a time. Also, significant interactions between the variables can be identified and quantified by this technique. RSM has been widely used to evaluate and understand the interactions between different physiological and nutritional parameters. A prior knowledge and understanding of these parameters are necessary for achieving a more realistic model [10]. The present study reports the effect of critical medium components on antibacterial metabolite production from a marine Streptomyces sp PUA2 using Placket Burmann design and Response Surface Methodology (RSM).
MATERIALS AND METHODS
Streptomyces sp PUA2 strain
Streptomyces sp. PUA2 was isolated from marine sediment collected from Andaman ecosystems (Lat. 11.68°N;Long 92.77°E) using starch casein agar medium. It produced dirty white powdery colonies with diffusible pigment production on ISP2 agar medium. Viability of strain PUA2 was maintained on ISP2 agar slants at 4°C. Crude ethyl acetate extract prepared from Streptomyces sp PUA2 showed promising activity against the gram positive and gram negative bacterial pathogens. In an earlier study, effect of critical medium components on bioactive metabolite production from Streptomyces sp PUA2 was determined by classical one factor at a time method [11].
Fig. 1: Growth of Streptomyces sp PUA2 on ISP2 agar
Inoculum preparation
Well grown culture of Streptomyces sp PUA2 was transferred in to 100 ml yeast extract malt extract (YEME) and kept in rotary shaker for 48 h. Basal medium consists of 1% glucose;1% yeast extract and 0.1% NaCl. The pH of the medium was adjusted to 7.0 prior to sterilization. Each 25 ml of basal medium was prepared and inoculated with different variables in respective concentrations.
Experimental procedure
Antibacterial activity of cell free supernatant was tested by agar well diffusion method. Previously cultured Staphylococcus aureus MTCC96 was inoculated on nutrient agar plates using sterile cotton swab. A 5 mm diameter well was made on the nutrient agar plates and loaded with 50 µl cell free supernatant. The inoculated plates were incubated at 37°C and were kept under observation for 24 hours for determining the zone of inhibition. Dry weight of biomass was estimated using preweighed tube and expressed in mg of biomass per ml of the medium.
Plackett Burmann Screening Design (PB)
PB design was used for screening the most significant factors affecting the production of antibacterial metabolites. Each independent variable was tested at high and low levels indicated by + and-respectively. Effect of variables on bioactive metabolite production was determined by applying a two level factorial design. Different combinations and sequence of process conditions were investigated to determine the growth conditions best suited for growth and biomass production [12]. High and low values were assigned for the selected variables. Plackett Burmann designs for the seven variables were assigned as X1, X2, X3, X4, X5, X6, and X7 at high and low levels in which two factors, X4 and X6 were designated as ‘dummy’ variables. The factors or independent variables considered for design include glucose (X1), glycerol (X2), soybean meal (X3), calcium carbonate(X4), manganese chloride (X5), peptone (X6) and pH (X7) respectively. The results obtained with classical experiments in the previous study [11] were used in the selection of independent and dummy variables.
Table 1: Medium components and test levels for plackett-burmann experiment
| Variables | Medium components | Low Level (-) | High Level (+) |
| X1 | Glucose | 0.5 | 1.5 |
| X2 | Glycerol | 0.5 | 1.5 |
| X3 | Manganese chloride | 0.05 | 0.15 |
| X4 | Calcium carbonate | 0.5 | 0.5 |
| X5 | Soybean Meal | 0.05 | 0.15 |
| X6 | Peptone | 0.5 | 0.5 |
| X7 | pH | 6 | 8 |
Response surface methodology using central composite design (CCD)
Central composite design is one of the response surface methodologies. For statistical calculations the variables Xi were coded as xi according to Equation 1.
Xi= (xi−x0)/Δxi,( i=1, 2, 3…k) ……… (1)
Where Xi is (dimensionless) coded value of the real variable xi, x0 is the realvalue of Xi at the center point (zero) level, and the Δxi is the step change value. Each variable in the design were coded at five levels-2,-1, 0, 1, and 2 with all variables taken at a central coded value of zero. Accordingly, a 24 factorial experiment design, with an axial point (10mm) and six replicated at the center point, with a total number of 30 experiments were employed. Second degree polynomials, which include all interaction term, were used to calculate the predicted response in equation 2.

Where Y represents response variables, β0 is the interception coefficient, βi coefficient of the linear effect, βii, the coefficient of quadratic effect and βij, the coefficient of interaction effect.
RESULT AND DISCUSSION
Optimization by Plackett Burmann method
Plackett-Burmann statistical design was applied to reflect the relative importance of various fermentation factors. Seven different variables including fermentation conditions and medium constitution were chose to perform this optimization process. Antibacterial activity was measured after 120 hours of incubation [13]. The design of independent variables coded with the corresponding medium composition values with high level (H) and low level (L). The high level of each variable was set far enough from the low level to identify which ingredients of the media have significant influence on the antibacterial metabolite production [14]. The main effect of each variable on antibacterial activity was estimated as the difference between both averages of measurements made at the high level and at the low level of that factor. The data given in Table 2 showed a wide variation from 0 to 8 mm of inhibition zone. The variation reflects the importance of medium optimization to attain higher productivity. The main effects of the examined factors on the antimicrobial activity were calculated shown in Table 3. According to the resulting effects of 7 variables on antibacterial activity, glycerol (X1),
Effect of sources and their interaction on biomass
For each trial carried out experimentally by the Plackett Burmann design for the different combination of high and low values, biomass were determined. Trial 2 recorded highest biomass weight (17.7 mg/mL) while trial 8 has lowest biomass weight (6 mg/mL) [17-18]. The values were shown in Table 2 and data were analyzed graphically in figure 2.
Optimization by Response Surface Methodology
The optimum concentrations of the individual components in the production medium for antibacterial compound production by Streptomyces sp PUA2 were further optimized by the Response Surface Methodology. According to this design, the total number of treatment combinations was 2K+2k+no where k is the number of independent variables and n0 is number of repetitions of experiment at centre point. Based on the results of PB design, four critical components of the production medium were selected. For RSM analysis based on CCD, 30 experiments were performed in triplicate. The coded levels of the independent variables are given in Table 4. A 24 factorial CCD was developed by design expert package version 9.0.2 with 8 axial points and 6 replicates at the center points leading to 30 runs [19]. Multiple regression analysis was applied on the experimental data by the CCD design. The Results were fitted with a second order full polynomial equation. The empirical relationship between antibacterial metabolite production and the four test variables n coded units obtained the application of RSM is given by below equation.
Table 2: Plackett burmann experimental design for evaluating factors influencing antibacterial metabolite production
| TrialNo | Variables | Antibacterial activity againstS. aureus MTCC96(mm) | Biomass(mg/mL) | ||||||
| X1 | X2 | X3 | X4 | X5 | X6 | X7 | |||
| 1 | H | H | H | L | H | L | L | 6.5 | 8.3 |
| 2 | L | H | H | H | L | H | L | 6 | 17.7 |
| 3 | L | L | H | H | H | L | H | 0 | 8.4 |
| 4 | H | L | L | H | H | H | L | 8 | 8.4 |
| 5 | L | H | L | L | H | H | H | 7 | 13.7 |
| 6 | H | L | H | L | L | H | H | 0 | 10 |
| 7 | H | H | L | H | L | L | H | 6 | 8.2 |
| 8 | L | L | L | L | L | L | L | 4 | 6 |
Table 3: Statistical calculations for plackett burmann method
| X1 | X2 | X3 | X4 | X5 | X6 | X7 | |
| Sum of [H] | 20.5 | 25.5 | 12.5 | 20 | 21.5 | 21 | 13 |
| Sum of [L] | 17 | 12 | 25 | 17.5 | 16 | 16.5 | 24.5 |
| Effect | 0.875 | 3.38 | -3.13 | 0.63 | 1.38 | 1.13 | -2.88 |
| MS | 1.531 | 22.78 | 19.53 | 0.78 | 3.78 | 2.53 | 16.53 |
| F-test | 0.92 | 13.80 | 11.83 | 0.472 | 2.29 | 1.53 | 10.01 |
MS-mean square;EMS-error mean square = 1.65, soybean meal (X3), pH (X7) and manganese chloride (X5) have significantly influenced antibacterial metabolite production and the dummy variables (X4 & X6) and glucose (X1) included in the design have a least effect on the antibacterial compound production based on F-test values. The mean square (variance of effect) showed higher value for glycerol. The highest antibacterial activity was recorded in trial 4 while the lowest antibacterial activity was in Trial 8 and no activity in Trial 5 and 6 [15-16].
Table 4: Range and levels of different process variables used in ccd for antibacterial activity
| Variables | -2 | -1 | 0 | 1 | 2 |
| Glycerol(X1) g/mL | 5 | 7.5 | 10 | 12.5 | 15 |
| Soybean meal (X2) g/mL | 5 | 7.5 | 10 | 12.5 | 15 |
| Manganese chloride (X3) g/mL | 0.5 | 0.75 | 1 | 1.25 | 1.5 |
| pH( X4) 1-9 | 5 | 6 | 7 | 8 | 9 |
Where Y is the measured response (antibacterial activity units in mm), X1, X2, X3 and X4 are the coded values of independent variables. CCD results on experiments with different combination for X1, X2, X3, and X4 are presented along with predicted and experimental values for antibacterial activity shown in table 5.
The coefficient of determination (R2) was found to be 0.755 for the antibacterial metabolite production, indicating 75.5 % of variability in the response could be explained by the statistical model. The closer the R2 is to 1.0, the stronger the model and the better it predicts the response. In this case, the value of the determination of coefficient elucidated the validity of the model. The adjusted R2 value corrects the R2 value for the sample size and for the number of terms in the model.

Fig. 2: Showing Biomass (mg/ml) vs. Trial no in Plackett Burmann Method.
The value of the adjusted determination coefficient (Adj R2 = 0.53) was also high supporting the significance of the model [20]. In this case the adjusted R2 was noticeably smaller than the R2 value since there are many variables in the model and their sample size was also not very large [21]. The coefficient of variation of model was 4.22% and the PRESS statistic value of 118.32 proved the validity of model.
There is a 38.03% chance that a lack of fit has occurred and this could be due to noise. Non-significant lack of fit is good for an apt model showing excellent optimization [22-23]. Response surface contour plots and their three dimensional graphs are employed to understand the relationship between the response and experimental values of each variable. These plots also showed the type of interaction between test variables and helped to obtain the optimum conditions [24]. A total of six response surface plots were obtained by the central composite design. Maximum zone of inhibition showing the antibacterial activity (12.09 mm) was found during the interaction of soybean meal and Glycerol by fixing the quantity of manganese chloride and pH (Fig.1a). The antibacterial activity was observed in terms of the zone of inhibition, 10.78 mm as shown in the Fig.1b at pH 7 and glycerol (10g/mL). Similar values of the inhibition zone were observed during the interaction of Manganese chloride (1g/mL) and glycerol (10g/ml). The zone of inhibition was 10.67 mm during this interaction (Fig.1c). A comparable inhibition zone of 12.01 mm (Fig.1d) was obtained at pH 7 and soybean meal (10g/ml),
The interaction of Manganese chloride (1gm/ml) and Soybean meal(10g/ml) showed an intermediate zone of inhibition, whose value was observed as 11mm (Fig 1e). Figure.1f shows the interaction between manganese chloride (1g/ml) and pH 7 and this interaction produced an inhibition zone of 11.5 mm [25-27].
Table 5: Central composite design matrix in coded values and responses
| Variables | Antibacterial activity against S.aureus MTCC96(mm) | |||||
| Run | X1 | X2 | X3 | X4 | Experimental value | Predicted value |
| 1 | -1 | -1 | -1 | -1 | 7 | 7.726 |
| 2 | 1 | -1 | -1 | -1 | 7 | 8.117 |
| 3 | -1 | 1 | -1 | -1 | 7 | 8.547 |
| 4 | 1 | 1 | -1 | -1 | 7 | 10.683 |
| 5 | -1 | -1 | 1 | -1 | 7 | 10.131 |
| 6 | 1 | -1 | 1 | -1 | 8 | 11.762 |
| 7 | -1 | 1 | 1 | -1 | 8 | 11.102 |
| 8 | 1 | 1 | 1 | -1 | 8 | 7.279 |
| 9 | -1 | -1 | -1 | 1 | 8 | 7.534 |
| 10 | 1 | -1 | -1 | 1 | 8 | 7.359 |
| 11 | -1 | 1 | -1 | 1 | 8 | 7.415 |
| 12 | 1 | 1 | -1 | 1 | 8 | 11.943 |
| 13 | -1 | -1 | 1 | 1 | 9 | 11.247 |
| 14 | 1 | -1 | 1 | 1 | 9 | 12.082 |
| 15 | -1 | 1 | 1 | 1 | 9 | 11.187 |
| 16 | 1 | 1 | 1 | 1 | 9 | 9.195 |
| 17 | -2 | 0 | 0 | 0 | 9 | 8.70 |
| 18 | 2 | 0 | 0 | 0 | 9 | 8.557 |
| 19 | 0 | 2 | 0 | 0 | 9 | 9.517 |
| 20 | 0 | -2 | 0 | 0 | 9 | 7.141 |
| 21 | 0 | 2 | 0 | 0 | 9 | 14.269 |
| 22 | 0 | 0 | 2 | 0 | 10 | 9.141 |
| 23 | 0 | 0 | -2 | 0 | 11 | 9.269 |
| 24 | 0 | 0 | 0 | -2 | 11 | 8.308 |
| 25 | 0 | 0 | 0 | 2 | 11 | 8.308 |
| 26 | 0 | 0 | 0 | 0 | 11 | 8.308 |
| 27 | 0 | 0 | 0 | 0 | 12 | 8.308 |
| 28 | 0 | 0 | 0 | 0 | 12 | 8.308 |
| 29 | 0 | 0 | 0 | 0 | 13 | 8.308 |
| 30 | 0 | 0 | 0 | 0 | 14 | 8.308 |
Table 6: Analysis of variance (anova), regression coefficient estimate and test of significance for antibacterial activity in mm (r1)
| Source | Sum of Squares | Df | F Value | P ValueProb > F |
| Model | 79.13 | 14 | 3.30 | 0.0141 |
| X1 | 0.17 | 1 | 0.097 | 0.7593 |
| X2 | 2.842×10-14 | 1 | 1.661×10-14 | 1.0000 |
| X3 | 4.17 | 1 | 2.44 | 0.1395 |
| X4 | 2.67 | 1 | 1.56 | 0.2310 |
| X12 | 32.19 | 1 | 18.81 | 0.0006 |
| X22 | 32.19 | 1 | 18.81 | 0.0006 |
| X32 | 25.19 | 1 | 14.72 | 0.0016 |
| X42 | 9.33 | 1 | 5.45 | 0.0338 |
| X1X2 | 4.263×10-14 | 1 | 2.492×10-14 | 1.0000 |
| X1X3 | 2.842×10-14 | 1 | 1.661×10-14 | 1.0000 |
| X1X4 | 2.842×10-14 | 1 | 1.661×10-14 | 1.0000 |
| X2X3 | 0.25 | 1 | 0.15 | 0.7076 |
| X2X4 | 0.25 | 1 | 0.15 | 0.7076 |
| X3X4 | 0.25 | 1 | 0.15 | 0.7076 |
| Residual | 25.67 | 15 | ||
| Lack of Fit | 18.83 | 10 | 1.38 | 0.3803 |
| Pure Error | 6.83 | 5 | ||
| Correlation Total | 104.80 | 29 |
Statistical significance of model was investigated by ANOVA as shown in Table 6. The F value of 3.30 implies the significance of the model. P values of the model (0.0141) indicate the significance of the model terms. In this case X12, X22, X32 and X42 are significant model terms. The p value of the Lack of fit term was 1.38 implying its non-significant relative to pure error.
In Response plots and contour diagrams (Fig.3), contour diagrams (Fig.1a,1d, 1e, 1f) were elliptical and tilted, indicating significant cross product interaction between the factors X1 and X2, X2 and X3, X2 and X4, X3 and X4 [28-29].This is also evident from coefficient estimate values (Table 6). Contour diagrams of Figure 1b and Figure 1d are elliptical but not tilted, indicating a good deal of negligible interaction between (X1 & X3 and X1 & X4). This implies that the linear effects of glycerol, manganese chloride and pH are significant. The interactive effect of soya bean meal with manganese chloride and pH is more significant than the other factors. These suggest that the concentrations of glycerol, manganese chloride and pH have a direct relationship with the production of antibiotic and creation of the zone of inhibition In the present study, the experimental results based on response surface approach clearly showed that the antibiotic production was dependent on the optimized values of the medium components taken into consideration [30-32].
 |
 |
 |
 |
 |
 |
Fig. 3: Response surface plots for Antibacterial activity:a) Soy bean meal vs. glycerol;b) pH vs. Glycerol;c) Manganese chloride vs. Glycerol;d) pH vs. Soy bean meal;e) Manganese chloride vs. Soybean meal;f) Manganese Chloride vs. pH
CONFLICT OF INTERESTS
Declared None
ACKNOWLEDGEMENT
Authors thank the authorities of Periyar University for the research facilities provided.
REFERENCES
- Lam KS. Discovery of novel metabolite from marine actinomycetes, Current Opinion in Microbiology 2006;9:245-51.
- Radhakrishnan M, Balagurunathan R, Selva Kumar N, Doble M, Vanaja Kumar. Bioprospecting of marine derived actinomycetes with special reference to antimycobacterial activity, Indian J Geo-Marine Sci 2011;40(3):407-10.
- Williams, P.G, Panning the chemical gold:marine bacteria as a source of new therapeutics. Trends Biotechnol 2009;27:45-52.
- Ripa FA, Nikkon F, Zaman S, Khondkar P. Optimal conditions for antimicrobial metabolites production from a new Streptomyces sp.RUPA-08PR isolated from Bangladesh soil. Mycobiology 2009;37(3):211-14.
- Kiranmayi MU, Sudhakar P, Sreenivasulu K, Vijayalakshmi M. Optimization of culturing conditions for improved production of bioactive metabolites by Pseudonocardia sp. VUK-10. Mycobiology 2011;39(3):174-81.
- Song Q, Huang Y, Yang H. Optimization of fermentation conditions for antibiotic production by actinomycetes YJ1 strain against Sclerotinia sclerotiorum. J Agri Sci 2012;4(7):95-102.
- Prakasham RS, Subba Rao R, Sreenivas Rao R, Rajesham S, Sarma PN. Optimization of alkaline protease production by Bacillus sp. using Taguchi methodology. Applied Biochemistry and Biotechnology 2005;120:133-44.
- Conley W. Computer Optimization Techniques. Revised ed. Petrocelli Books:Princeton NJ, 1984;147-63.
- Yasser R, Abdel-Fattah, Saeed HM, Gohar YM, El-Baz MA. Improved production of Pseudomonas aeruginosa uricase by optimization of process parameters through statistical experimental designs. Process Biochemistry 2005;40(5):1707-714.
- Box GEP, Hunter WG, Hunter JS, Statistics for Experimenters. An Introduction to Design, Data Analysis and Model Building, New York:John Wiley and Sons, 1978.
- Shekar P, Anuradha J, Radhakrishnan M, Balagurunathan R. Effect of critical medium components on antimicrobial compound production from marine Streptomyces species(A2) by one factor at a time method. J Chem Pharm 2011;3(6):872-76.
- Bashir ZM, Ahmad A, Nor SM, Usup G. Factors affecting bioactivity of secondary metabolites produced by Streptomyces sp. PT1 using Plackett-Burman design. Advance in Environmental Biology 2012;6(12):3043-51.
- Vijayakumar R, Paneerselvam K, Muthukumar C, Thajuddin N, Paneerselvam A, Saravanamuthu R. Optimization of antimicrobial production by a marine actinomycete Streptomyces afghaniensis VPTS3-1 isolated from Palk Strait, East Coast of India. Indian J Microbiol 2012;52(2):230-39.
- Jian Z, Fa GN. Application of response surface methodology in medium optimization for pyruvic acid production of Torulopsis glabrata TP19 in batch fermentation. Journal of Zhejiang University SCIENCE B 2007;8(2):98-104.
- Sharma D, Manhas RK. Application of Plackett–Burman experimental design and Box and Wilson design to improve broad-spectrum antimicrobial compound. Indian Journal of Biotechnology 2013;12:386-94.
- Anuradha Jabasingh S, Valli Nachiyar C. A new combinational statistical approach for cellulase optimization in Aspergillus nidulans. Indian Journal of Science and Technology, 2010;3(8):871-78.
- El-Sersy NA, Abd-Elnaby H, Abou-Elela GM, Hibrahin HA, EI-Toukhy NMK. Optimization, economization and characterization of cellulase produced by marine Streptomyces ruber. African Journal of Biotechnology 2010;9(38):6355-364.
- Liu GQ, Wang XL. Optimization of critical medium components using response surface methodology for biomass and extracellular polysaccharide production by Agaricus blazei. Appl Microbiol Biotechnol 2007;74:78-83.
- Khuri AI, Cornell JA. Response Surfaces:designs and analysis, Marcel Decker, New York, NY, USA, 1987.
- Himabindu M, Ravichandra P, Vishalakshi K, Jetty A. Optimization of critical medium components for the maximal production of Gentamicin by Micromonospora echinospora ATCC 15838 using Response Surface Methodology. Applied Biochemistry and Biotechnology 2006;134:143-53.
- Anuradha Jabasingh S, Pavithra G. Response surface approach for the biosorption of Cr6+ ions by Mucor racemosus Clean—Soil Air Water 2010;38(5-6):492–99.
- Shi LE, Qing G, Zhang XY, Tang ZX, Chen JS, Xiong WY, Liu HZ. Medium optimization for 5’-phosphodiesterase production from Penicillium citrinum using Response Surface Methodology. Food Technol Biotechnol 2007;45(2):126-33.
- Jia B, Jin ZH, Mei LH. Medium optimization based on statistical methodologies for Pristinamycins production by Streptomyces pristinaespiralis. Appl Biochem Biotechnol 2008;144:133-43.
- Haaland PD, Experimental design in Biotechnology, New York:Marcel Dekker;separating signals from the noise, 61–83;1989.
- Cao Y, Meng DJ, Lu J, Long J. Statistical optimization of xylanase production by Aspergillus niger AN-13 under submerged fermentation using response surface methodology. African Journal of Biotechnology 2008;7(5):631-38.
- Song S, Wei R, Zhang B, Wang D. optimization of the antibacterial activity of half-fin anchovy (setipinna taty) hydrolysates. Food Bioprocess Technol 2012;5:1979-989.
- Amanda S, Motta, Brandelli A. Evaluation of environment conditions for productions of bacteriocin-like substance by Bacillus sp. strain P34. World J Microbiol Biotechnol 2008;24:641-46.
- Anuradha Jabasingh S, Valli Nachiyar C. Optimization of cellulase synthesis by RSM and evaluation of ethanol production from enzymatically hydrolysed sugarcane bagasse using Saccharomyces cerevisiae. J Scientific and Industrial Res 2012;71:353-59.
- Wang YH, Feng JT, Zhang Q, Zhang X. Optimization of fermentation condition for antibiotic production by Xenorhabdus nematophila with Response Surface Methodology. J Applied Microbiology 2008;104:735-44.
- Anuradha Jabasingh S. Optimization and kinetics of cellulase immobilization on modified chitin using Response Surface Methodology. Adsorption Science & Technology 2011;29(9):897-915.
- Anuradha Jabasingh S, Varma S, Pavithra G. Response Surface Methodology for the evaluation and comparison of cellulase production by Aspergillus nidulans SU04 and Aspergillus nidulans MTCC 344 cultivated on pretreated suguarcane bagasse. Chemical and Biochemical Engineering Quarterly 2014;28(1):127-35.
- Anuradha Jabasingh S. Utilization of pretreated coir pith for the optimized bioproduction of cellulose by Aspergillus nidulans. International Biodeterioration & Biodegradation, 2011;65:1150-60.